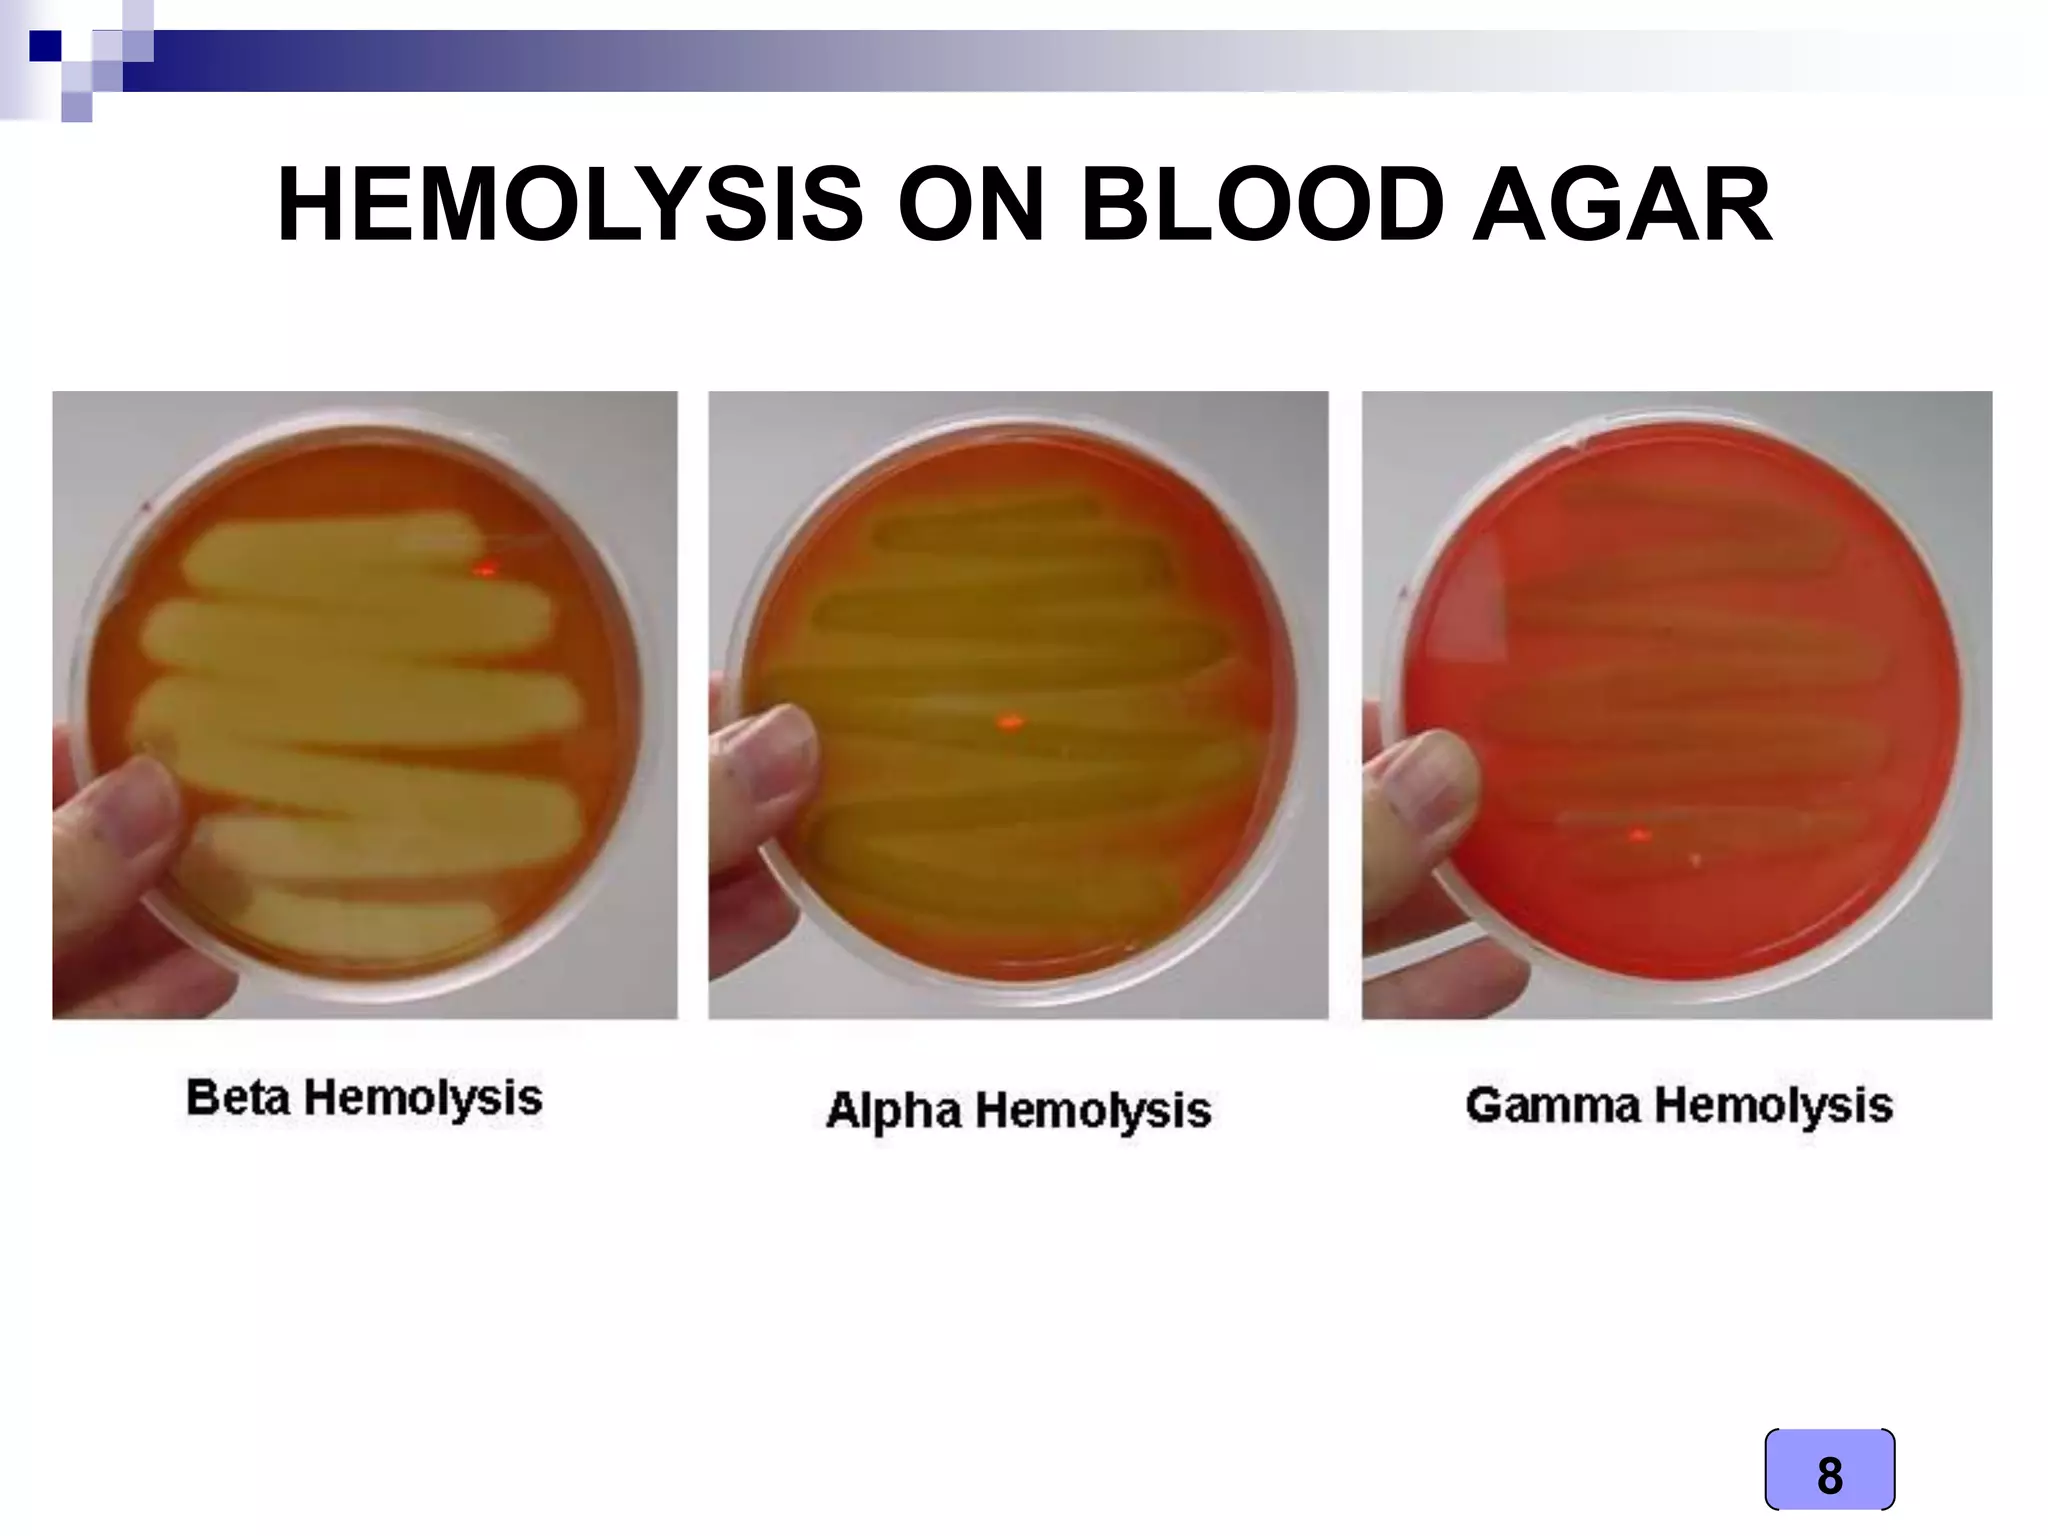
8
HEMOLYSIS ON BLOOD AGAR
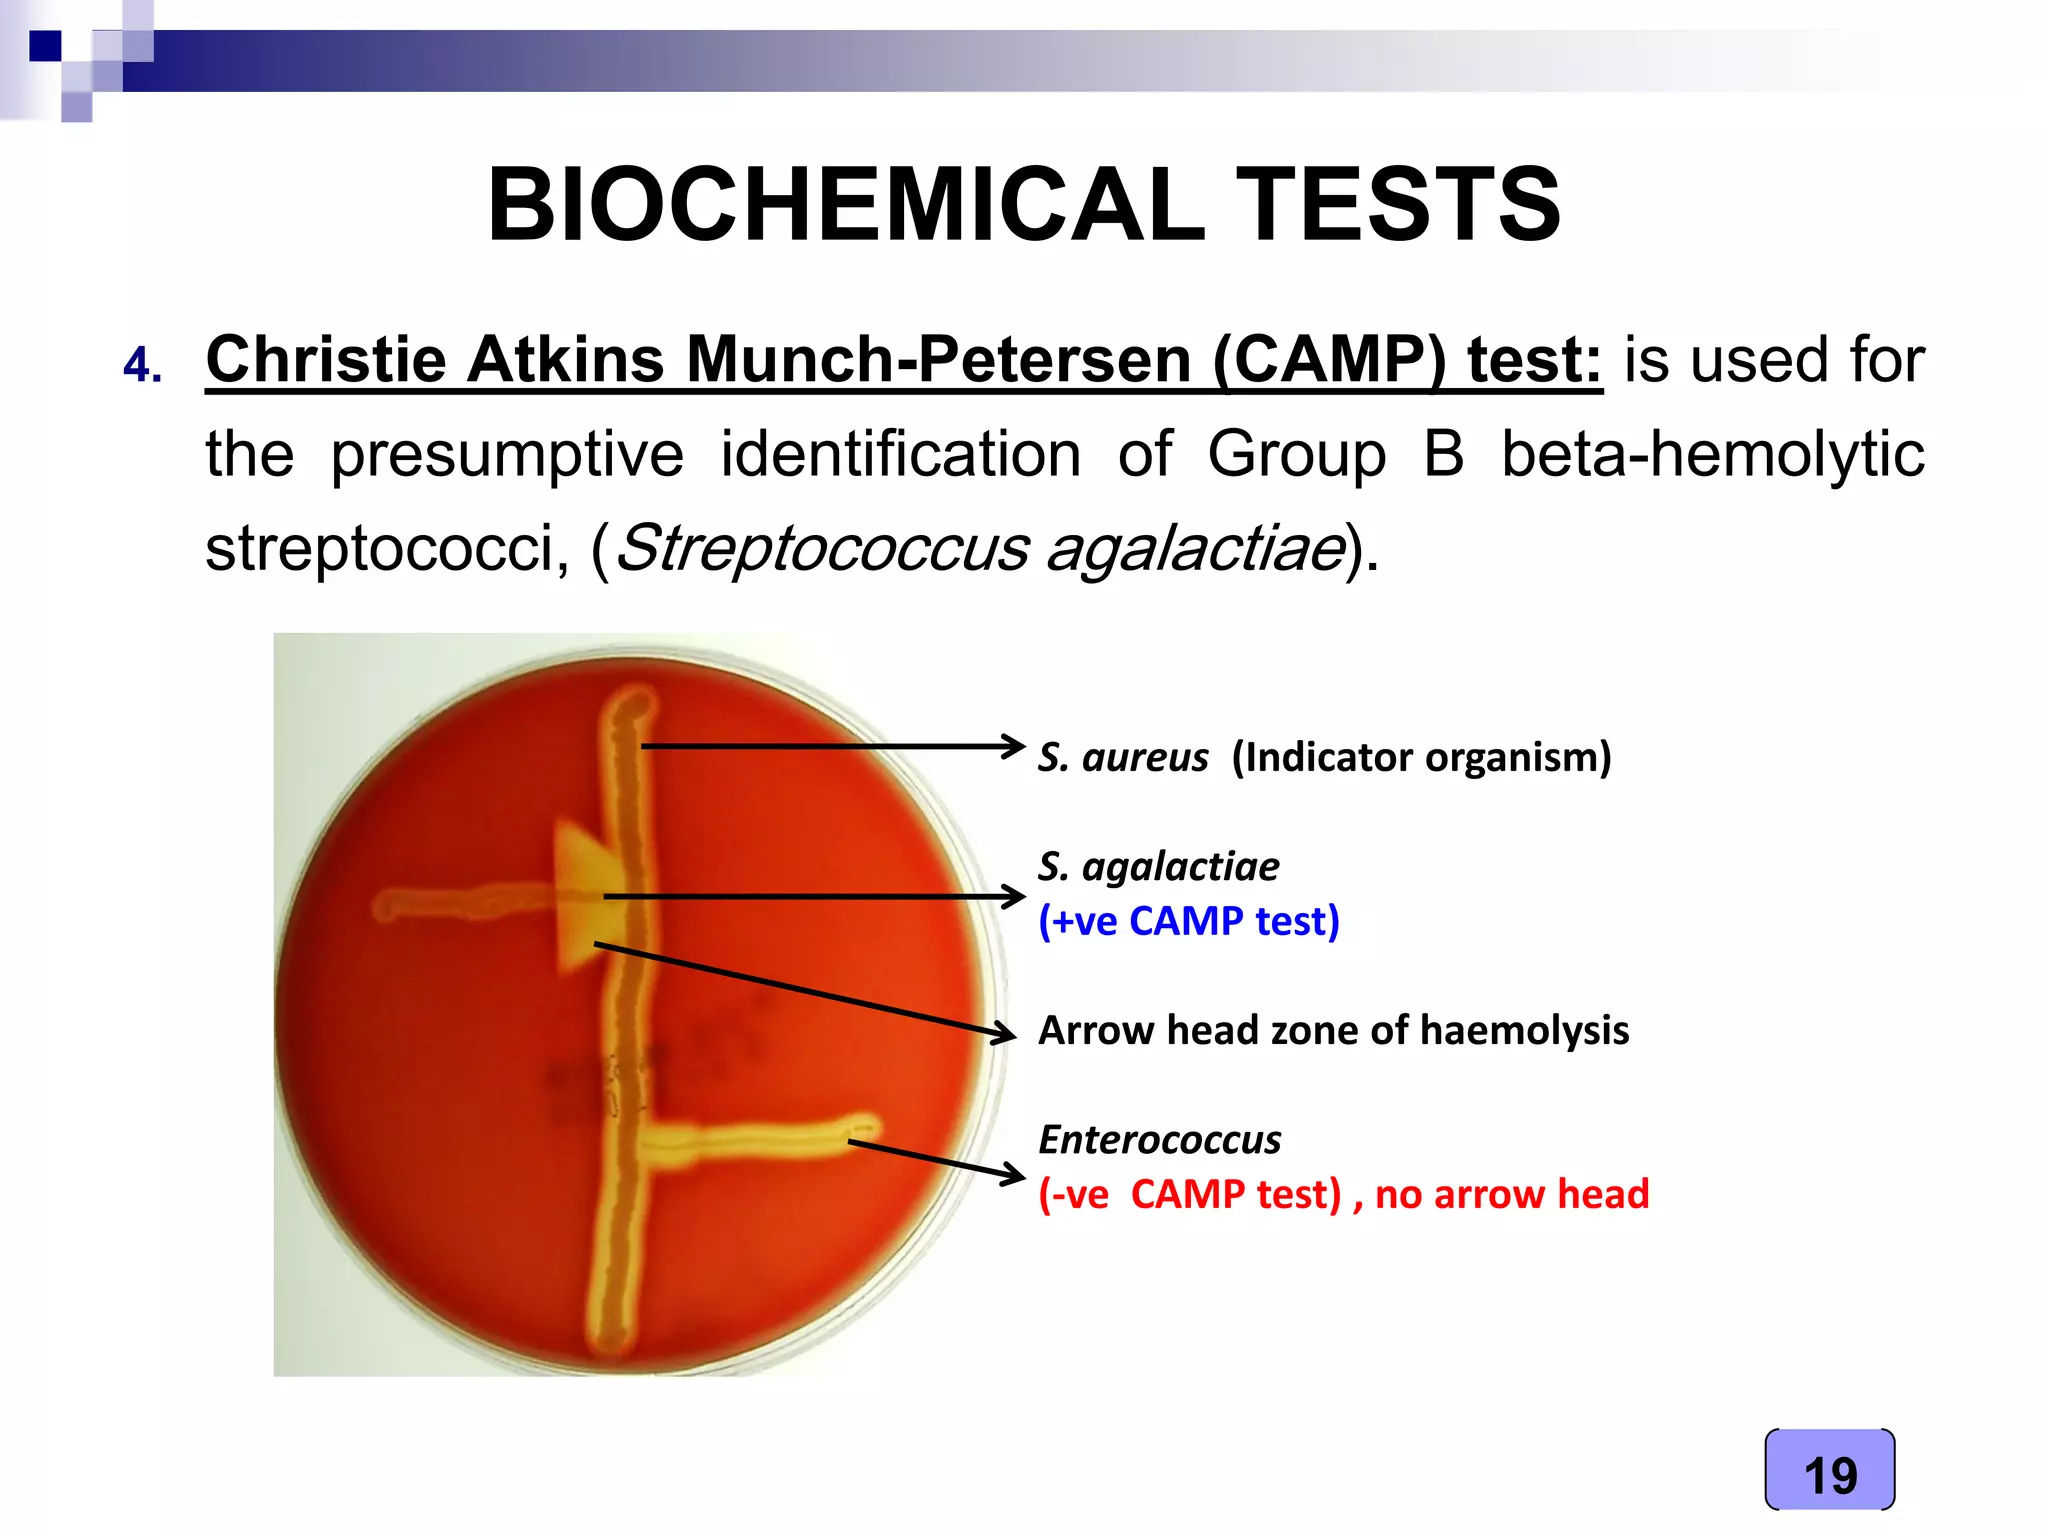
19
BIOCHEMICAL TESTS
4. Christie Atkins Munch-Petersen (CAMP) test: is used for
the presumptive identification of Group B beta-hemolytic
streptococci, (Streptococcus agalactiae).
S. aureus (Indicator organism)
S. agalactiae
(+ve CAMP test)
Arrow head zone of haemolysis
Enterococcus
(-ve CAMP test) , no arrow head

This document provides an overview of Streptococcus bacteria, including characteristics, diseases caused, taxonomy, and methods for identification. Key points include:
- Streptococcus is a genus of spherical, Gram-positive bacteria that grow in chains. It includes over 50 species that are part of normal oral flora but can also cause diseases.
- Major diseases caused by different Streptococcus species include pharyngitis, pneumonia, toxic shock syndrome, and neonatal infections.
- Identification involves examining colony morphology on blood agar plates, microscopic appearance, and biochemical tests like catalase, optochin, and bile esculin tests.
- Classification is based on carbohydrate antigens identified through Lancefield grouping